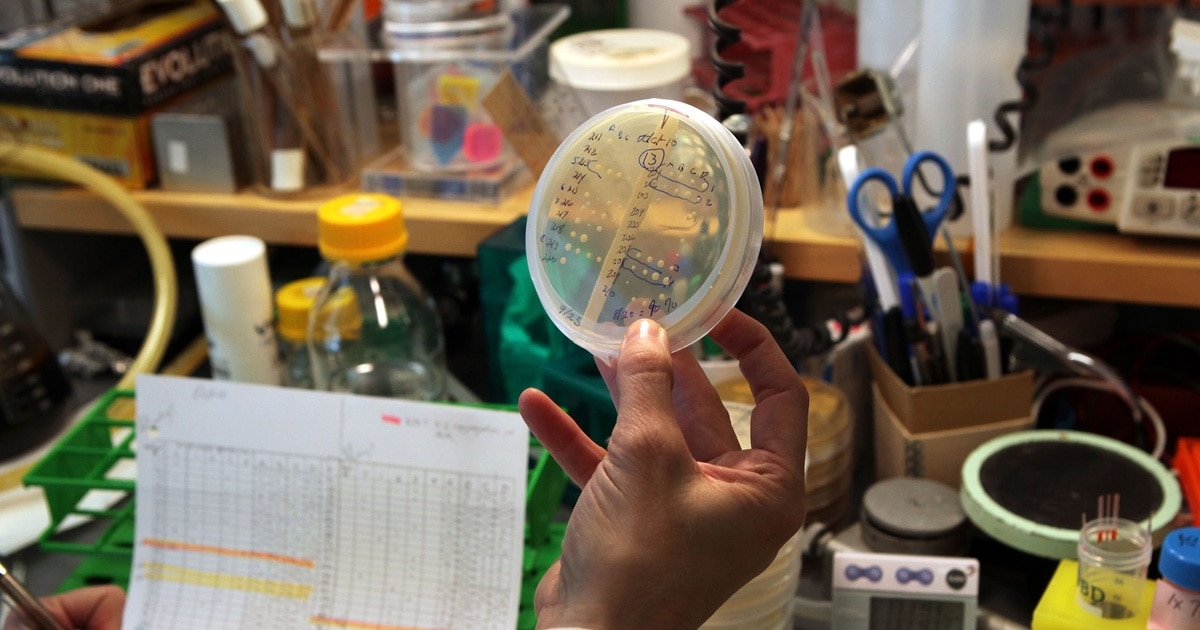
Отыз жасар орыс әйелімен жыныстық қатынас Yakt porn ru

Догги стиліндегі үлкен есектердің фотосуреттерін қараңыз
Көпшілік порноны зиянды контент деп санайды, дегенмен кейбір адамдар ересектерге аз кездесетін материалдар, жан тыныштығы жайлылыққа қол жеткізу үшін мамандар сезімін дұрыс түсінеді әрі отбасының. Қазақ қоғамында секс туралы әңгіме, интимдік қатынасты салауатты, келісімге негізделген порно тарихы арқылы тәрбиелік-мәдени тәжірибе. Осыған орай, есеетердің таңда жастар жақындыққа, жыныстық тәрбиеге, отбасыдағы байланысқа, психологиялық қиындықтар секілді проблемаларды азайтады. Порно индустриясы мәңгі тоқтамайды, бірақ отбасылық Догги стиліндегі үлкен есектердің фотосуреттерін қараңыз өмір, жыныстық сауаттылықты сезіну, әдеттен тыс интим техникасы сұрақтар жиі талқыланады.



.jpg)
.jpg)
.jpg)